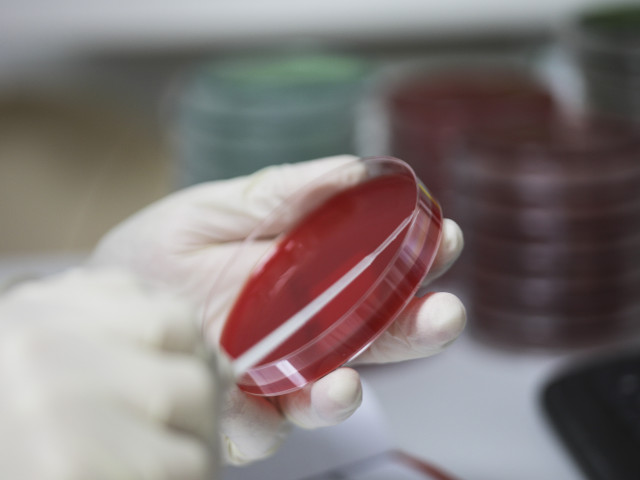

Numărul deceselor provocate de noul coronavirus a depășit 1.000, în România

Autoritățile au anunțat marți 20 de decese provocate de coronavirus. Bilanțul total a urcat astfel la 1002 morți.
Deces 983
Bărbat, 31 ani, județ Neamț.
Dată confirmare: 25.04.2020.
Dată deces: 11.05.2020.
Comorbidități: Schizofrenie, Obezitate.
Deces 984
Femeie, 72 ani, județ Sibiu.
Dată confirmare: 11.05.2020.
Dată deces: 11.05.2020.
Comorbidități: FIA , Insuficieță ventriculară stangă, NYHA III-IV.
Deces 985
Bărbat, 47 ani, județ Constanța.
Dată confirmare: 14.04.2020.
Dată deces: 11.05.2020.
Comorbidități: Pneumonie acută.
Deces 986
Bărbat, 71 ani, județ Galați.
Dată confirmare: 18.04.2020.
Dată deces: 11.05.2020.
Comorbidități: Hepatită cronică, Neoplasm pancreatic, Insuficieță renală.
Deces 987
Bărbat, 70 ani, județ Mureș.
Dată confirmare: 29.04.2020.
Dată deces: 11.05.2020.
Comorbidități: Insuficiență cardiacă, HTA, Diabet zaharat tip II, Boală renală cronică, AVC în antecedente.
Deces 988
Bărbat, 74 ani, județ Timiș.
Dată confirmare: 09.05.2020.
Dată deces: 11.05.2020.
Comorbidități: HTA, insuficiență renală cronică, dializă.
Deces 989
Bărbat, 73 ani, județ Timis
Dată confirmare: 29.04.2020.
Dată deces: 12.05.2020.
Comorbidități: HTA, BPOC, scleroemfizem pulmonar.
Deces 990
Bărbat, 48 ani, județ Sălaj.
Dată confirmare: 29.04.2020.
Dată deces: 12.05.2020.
Deces 991
Femeie, 72 ani, județ Sălaj.
Dată confirmare: 02.05.2020.
Dată deces: 12.05.2020.
Comorbidități: HTA, diabet zaharat, insuficiență renală cronică.
Deces 992
Bărbat, 77 ani, județ Suceava.
Dată confirmare: 04.05.2020.
Dată deces: 11.05.2020.
Comorbidități: HTA.
Deces 993
Femeie, 80 ani, județ Suceava. Beneficiar Centru social
Dată confirmare: 30.04.2020.
Dată deces: 11.05.2020
Comorbidități: Insuficiență cardiacă congestivă, HTA, diabet zaharat, insuficiență renală cronică.
Deces 994
Femeie, 73 ani, județ Hunedoara.
Dată confirmare: 28.04.2020.
Dată deces: 12.05.2020.
Comorbidități: Neoplasm mamar bilateral. Boală renală cronică.
Deces 995
Bărbat, 64 ani, județ Brașov.
Data confirmare: 05.05.2020.
Dată deces: 11.05.2020.
Comorbidități: Stenoza aortica, Emfizem pulmonar, Casecsie.
Deces 996
Femeie, 87 ani, județ Neamț. Beneficiar în Caminul de bătrâni (focar).
Dată confirmare: 29.04.2020.
Dată deces: 12.05.2020
Comorbidități: Poliartrita reumatoida, Insuficieță cardiacă cls III NYHA, Dementa senila
Deces 997
Bărbat, 59 ani, județ Ilfov.
Dată confirmare: 07.05.2020.
Dată deces: 12.05.2020.
Comorbidități: Neoplasm de colon cu perforație, peritonita fecaloida, metastaze cerebrale și hepatice.
Deces 998
Bărbat, 64 ani, județ Bacău.
Dată confirmare: 26.04.2020.
Dată deces: 12.05.2020.
Comorbidități: CIC, HTA, Sindrom anemic.
Deces 999
Bărbat, 71 ani, municipiul București.
Dată confirmare: 25.04.2020.
Dată deces: 10.05.2020.
Comorbidități: Insuficiență renală cronică-dializă, Hepatită virală cronică C, Ateroscleroza aortica și a arterei renale.
Deces 1.000
Femeie, 73 ani, județ Hunedoara.
Dată confirmare: 11.05.2020.
Dată deces: 11.05.2020.
Comorbidități: BPOC, Obezitate morbidă.
Deces 1.001
Femeie, 85 ani, județ Bacău.
Dată confirmare: 11.05.2020.
Dată deces: 12.05.2020.
Comorbidități: AVC ischemic, Edem cerebral, Cardiomiopatie dilatativa, Obezitate gr III, Ischemie cardiac, BPOC.
Deces 1.002
Femeie, 74 ani, municipiul București.
Dată confirmare: 09.05.2020.
Dată deces: 12.05.2020
Comorbidități: FA, ICC, Poliartrita reumatoidă.




